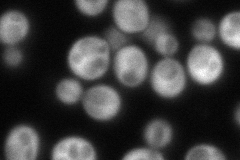
YJR049C
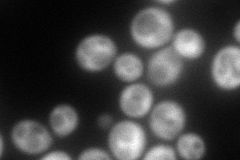
YJR049C
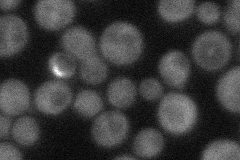
YJR049C
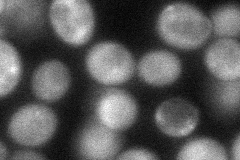
YJR049C

View description
ATP-NADH kinase; phosphorylates both NAD and NADH; active as a hexamer; enhances the activity of ferric reductase (Fre1p)
Localization:
Intensity:
Fold change:
Significance:
-
C’ GFP library in SD

below threshold14.57 -
N' NOP1pr-GFP in SD
cytosol168.891 -
N' TEF2pr-mCherry in SD
cytosol176.141 -
N' NATIVEpr-GFP in SD
cytosol34.9171 -
N' TEF2pr-VC and Cyto-VN in SD
cytosol54.3366 -
C’ GFP library in SD+DTT

cytosol17.541.2No -
C’ GFP library in SD+H2O2

cytosol16.681.14No -
C’ GFP library in Starvation Media

cytosol17.781.21No -
C’ GFP library on the background of Pup2-DaMP

below threshold -
C’ GFP library on the background of CCT mutant

below threshold16.61131.13942No
